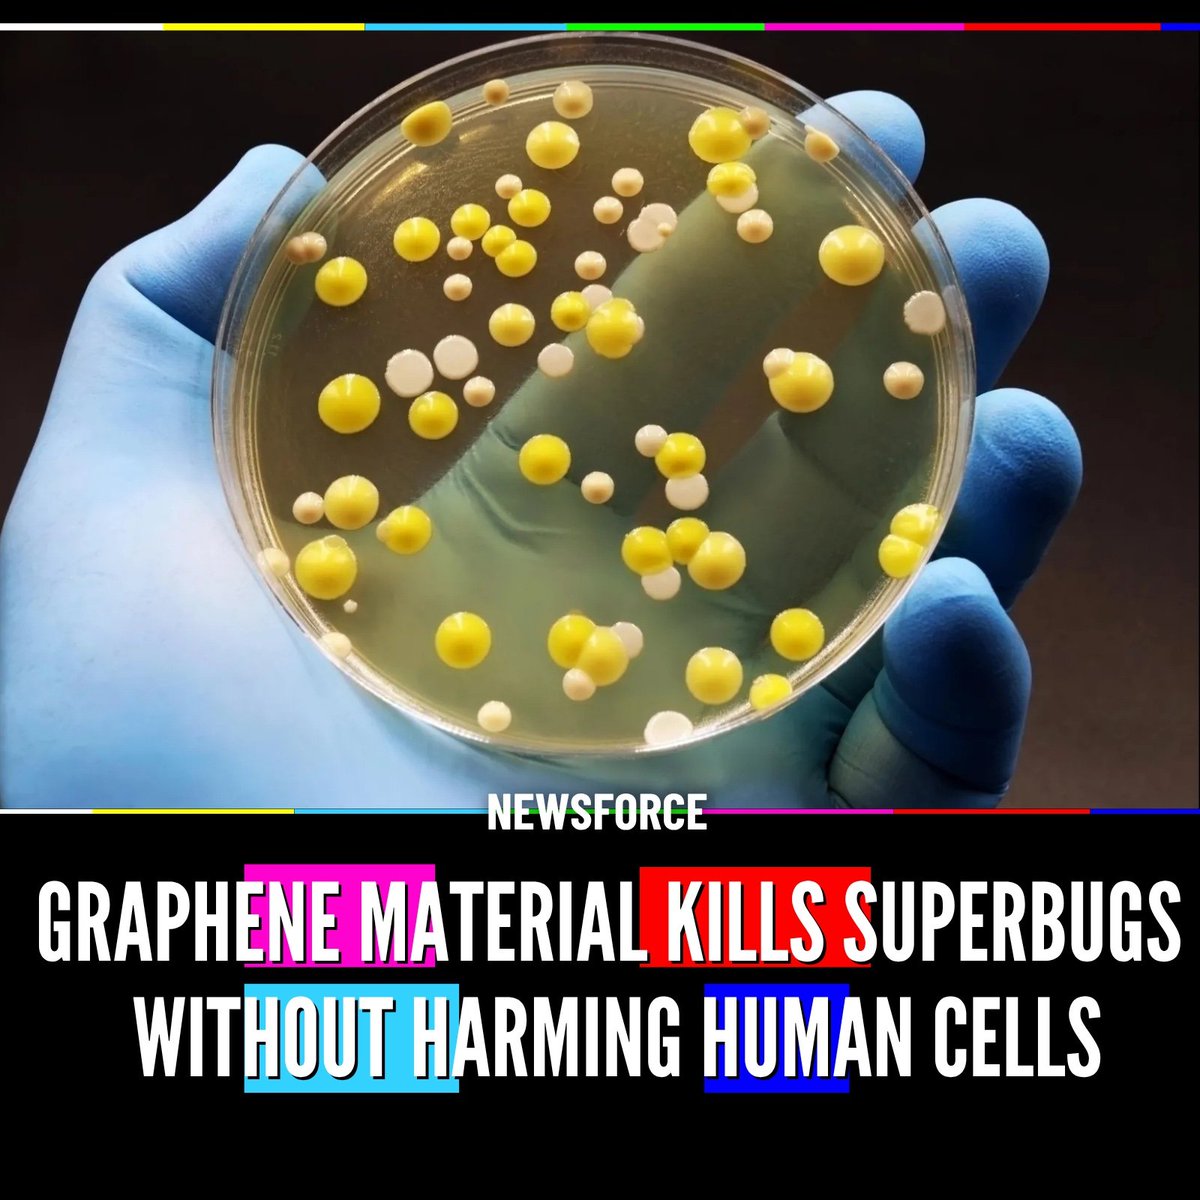
NewsForce tweet media

Angehefteter Tweet
Reality Co-Creation
6.5K posts


Reality Co-Creation
@RealityCoCreate
WWG1WGA. We all co-create reality with Universal Mind, knowingly or not. 'Life & Teaching of the Masters', Baird Spaulding. Neville Goddard Core Teachings.
Idaho, USA Beigetreten Haziran 2023
275 Folgt309 Follower

@HustleBitch_ Good catch. He has the exact same teeth same hair.
Same chubby, same eyes, same smile and lips, same beard.
They have been building people.
English

@TheInfoBlock Maybe amongst those 6000 classified patents?
English

@RealityCoCreate @Luizmd It's time you stopped believing grifting quacks.
English

@BoxerLock @george18kennedy No, do you CK's height? About JDs height? - except that assumes both EKs are the same person... And I have several different pics of CK - no way of knowing the diff heights.


English

@DeniseB_Epic @ninoboxer I've collected the "Trump" pics over the years. Don't know where any came from specifically.
English

@RealityCoCreate @ninoboxer Is that picture of Trump in the Q drops?
English

@oz_veteran @ClaytonMorris "polls" seem always convenient to the narrative. I ignore them now.
English

@RealityCoCreate @ClaytonMorris Conveniently, this occurred as Trump's polling numbers are at an all time low.
English

@RealityCoCreate @george18kennedy The CK we saw wasn't real..He was a criminal..LESSON...DON'T merely Follow The Leader ‼️‼️‼️THINK FOR YOURSELF..Like "DARK MAGA"--"ELON" 🤦🏼♀️Another CRIMINAL!
English

@SueHilary7849 @george18kennedy I've always wondered about these pics from years ago about CK. When was he swapped out?



English

They said cancer is random.
They said it’s genetic.
They said it’s just bad luck.
Then a scientist named Hulda Clark came out and said:
👉 “It’s parasites… and toxins.” 🪱 🦠
Her solution?
3 herbs:
🌳 Black Walnut
🌿 Wormwood
🌸 Cloves
No chemo.
No radiation.
No billion-dollar treatments.
Just a protocol.
Crazy?
Maybe.
But ask yourself…
Why are parasites never part of the conversation?

English

@NicHulscher Use ivermectin. Can't get any cancer cells.
issuu.com/magicvalleynew…
English

FROG GUT MICROBE ELIMINATES 100% OF CANCEROUS TUMORS AFTER SINGLE DOSE IN MICE
They re-introduced cancer into the cured animals... and the tumors COULDN'T GROW.
Ewingella americana targeted and eliminated cancer cells via DIRECT tumor destruction AND potent immune activation.
The study found NO detectable toxicity at effective doses, and it dramatically outperformed BOTH chemotherapy and immunotherapy.
@jimmy_dore
English

@SharrellAnne2 @drawandstrike People don't believe EK is how the actual EK would act. They are dissing the double who's done everything the opposite of what CK would have wanted and believed in.



English

I don’t even know what to say anymore watching this make the rounds.
4.6 million views. Hundreds of thousands of likes.
For mocking a woman who just walked out shaken after what happened last night.
And what gets me isn’t just the strangers. I’m seeing people I’ve known for years jump on this train of hating Erika like it’s normal. Like it’s deserved. For what?
Charlie was building something powerful. And he’s gone. Taken by someone who had the same kind of mindset we just saw play out again. And now his wife is being escorted out in the middle of all of this, clearly shaken, and instead of any level of decency, the internet turns it into a joke.
Make that make sense.
All of this anger, all of this energy, and it’s being aimed at the wrong person. Not at the people who create this kind of chaos. Not at the ones who actually push things to that level. It gets dumped on the easiest target… the one who’s already carrying more than most people could handle.
I’m tired of it.
Erika doesn’t deserve this. Nobody does. 😭

English

@Newsforce Excuse me!?! GO was in the jabs and ruptures the cells..
Graphene oxide (GO) is a 2D material with sharp, nanoscopic edges capable of damaging biological membranes, and can cause hemolysis (rupturing red blood cells) and provoke blood clotting or immune reactions.



English

🚨GRAPHENE MATERIAL KILLS SUPERBUGS WITHOUT HARMING HUMAN CELLS
Scientists found graphene oxide targets bacteria by binding to molecules unique to their cell membranes.
The material breaks down bacterial cells while leaving human cells unaffected due to structural differences.
Tests showed it can stop antibiotic-resistant bacteria and support faster wound healing in animals.
The antibacterial effect remained after repeated washing, with applications already used in consumer products.
English

@scitechgirl Take ivermectin and no "cures" needed.
issuu.com/magicvalleynew…
English

🚨 DNA “Smart Bomb” Targets Cancer Cells Like Nothing Before…
Scientists at the University of Geneva built a programmable DNA drug that only activates inside cancer cells. It works like a tiny logic machine, reading cancer signals and releasing medicine only where it’s needed — leaving healthy cells untouched. Tested in labs, it’s not yet a treatment, but it could revolutionize cancer therapy.
Source:
Université de Genève. (2026). Scientists create “smart” DNA drug that targets cancer cells with extreme precision. ScienceDaily

English

Fetterman calls on Democrats to 'drop the TDS and build the White House ballroom' after shooting justthenews.com/node/179241?ut…
English

@drawandstrike @PhoenixLady51 It seems this time "Q" set it up in case they needed it? (Henry post) Staff seem to know. Trump knows. Kariline said "shots fired" in presser day before..


English

We've got too many people building brands and followings for an echo chamber where they sit around and chortle over how Trump is faking everything, including assassination attempts.
Anons were to wake people up and get them involved in taking the country back.
Sitting in an echo chamber for 'Anons only!' and discussing how fake and ghey everything Trump and his team are doing was NOT the fucking mission.
⚔️⚖️The Justice Cometh⚖️⚔️@justicecometh
English

@OG_DrC @justicecometh Talking point for secure ballroom - maybe get lawsuit against it stopped? I'd call it a false flag to gain a talking point. Set up began Dec 21, 2023... Planned (IMO just in case it was needed?) We'll watch to see what happens...


English





























